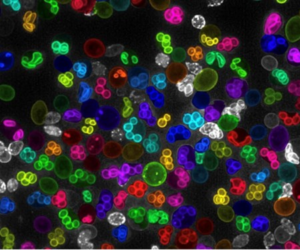

EFFORTS OF UNIVERSITY OF TSUKUBA筑波大学の取り組み
12件/260件中を表示

金原子核衝突実験により理論的に予測される量子色力学臨界点の存在を示唆

ヒト転写因子データの未測定範囲を体系化し研究戦略を提示

特殊なダイヤモンドの針を開発し超高速で変化する電場の局所計測に成功

麹菌の酵素生産能の高さは菌糸細胞体積と核数の増加による
AI技術で重なり合った細胞膜を正確に識別・定量する新手法を開発

月面電波望遠鏡でダークマターの正体に迫るには

神経細胞の微細な三次元構造の観察精度を10倍高める手法を開発

鉄酸化物薄膜作成中にリアルタイムでその性質を解析する技術を開発

放射線の種類で変化するEu添加CaF₂結晶の発光特性を発見

乳がん転移を導く「がん細胞-免疫細胞間シグナル」を解明

導電性高分子のファラデー回転を制御する新手法を発見

急性の心筋梗塞・腎障害と慢性臓器不全への進展に対する新規治療薬を開発